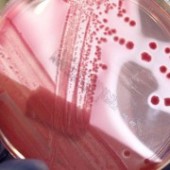
Przygotowanie do badań

TARCZYCA I JEJ HORMONY
Tarczyca jest jednym z narządów, który odpowiada za funkcjonowanie praktycznie wszystkich komórek w naszym organizmie. Jej prawidłowa praca wpływa zarówno na rozwój umysłowy i motoryczny dzieci jak i na zdrowie dorosłego organizmu.
Synteza i wydzielanie hormonów tarczycy, uzależnione jest od dwóch czynników: dostarczanego do organizmu jodu oraz działania hormonu TSH (tyreotropiny) produkowanego przez przysadkę mózgową. Tarczyca produkuje niezbędne dla życia hormony takie jak: trójjodotyroninę (T3), tyroksynę (T 4) i kalcytoninę (Ct). Gruczoł ten wydziela również tyreoglobulinę (Tg).
Trójjodotyronina (T3)
jest szczególnie istotna w okresie rozwoju ośrodkowego układu nerwowego. Niedobór tego hormonu w okresie niemowlęcym może prowadzić do nieodwracalnych zmian w mózgu czego następstwem może być niedorozwój umysłowy.
Tyroksyna (T4)
hormon ten jest bardzo ważny dla rozwoju psychicznego i fizycznego młodych organizmów, jak również wpływa na laktację i rozród, poprzez regulację czynności gruczołów płciowych. Niedobór tyroksyny może być przyczyną tzw. kretynizmu u dzieci. U dorosłych prowadzi do ogólnego osłabienia i spowolnienia organizmu. Nadmiar tego hormonu świadczy o nadczynności tarczycy i również ma niekorzystne konsekwencje.
Kalcytonina (Ct)
powoduje obniżenie poziomu wapnia we krwi m.in. przez odkładanie się tego pierwiastka w kościach, co zapobiega osteoporozie.
Tyreoglobulina (Tg)
produkowana jest zarówno przez komórki prawidłowo funkcjonującej tarczycy jak i przez gruczoł zmieniony nowotworowo. Znaczące przekroczenie normy stężenia tyreoglobuliny we krwi jest traktowane jako wskaźnik nowotworów tarczycy.
Diagnostyka medyczna pozwala szybko rozpoznać choroby tarczycy, poprzez wykonanie prostego badania hormonalnego krwi obejmującego: TSH, FT3, FT4.